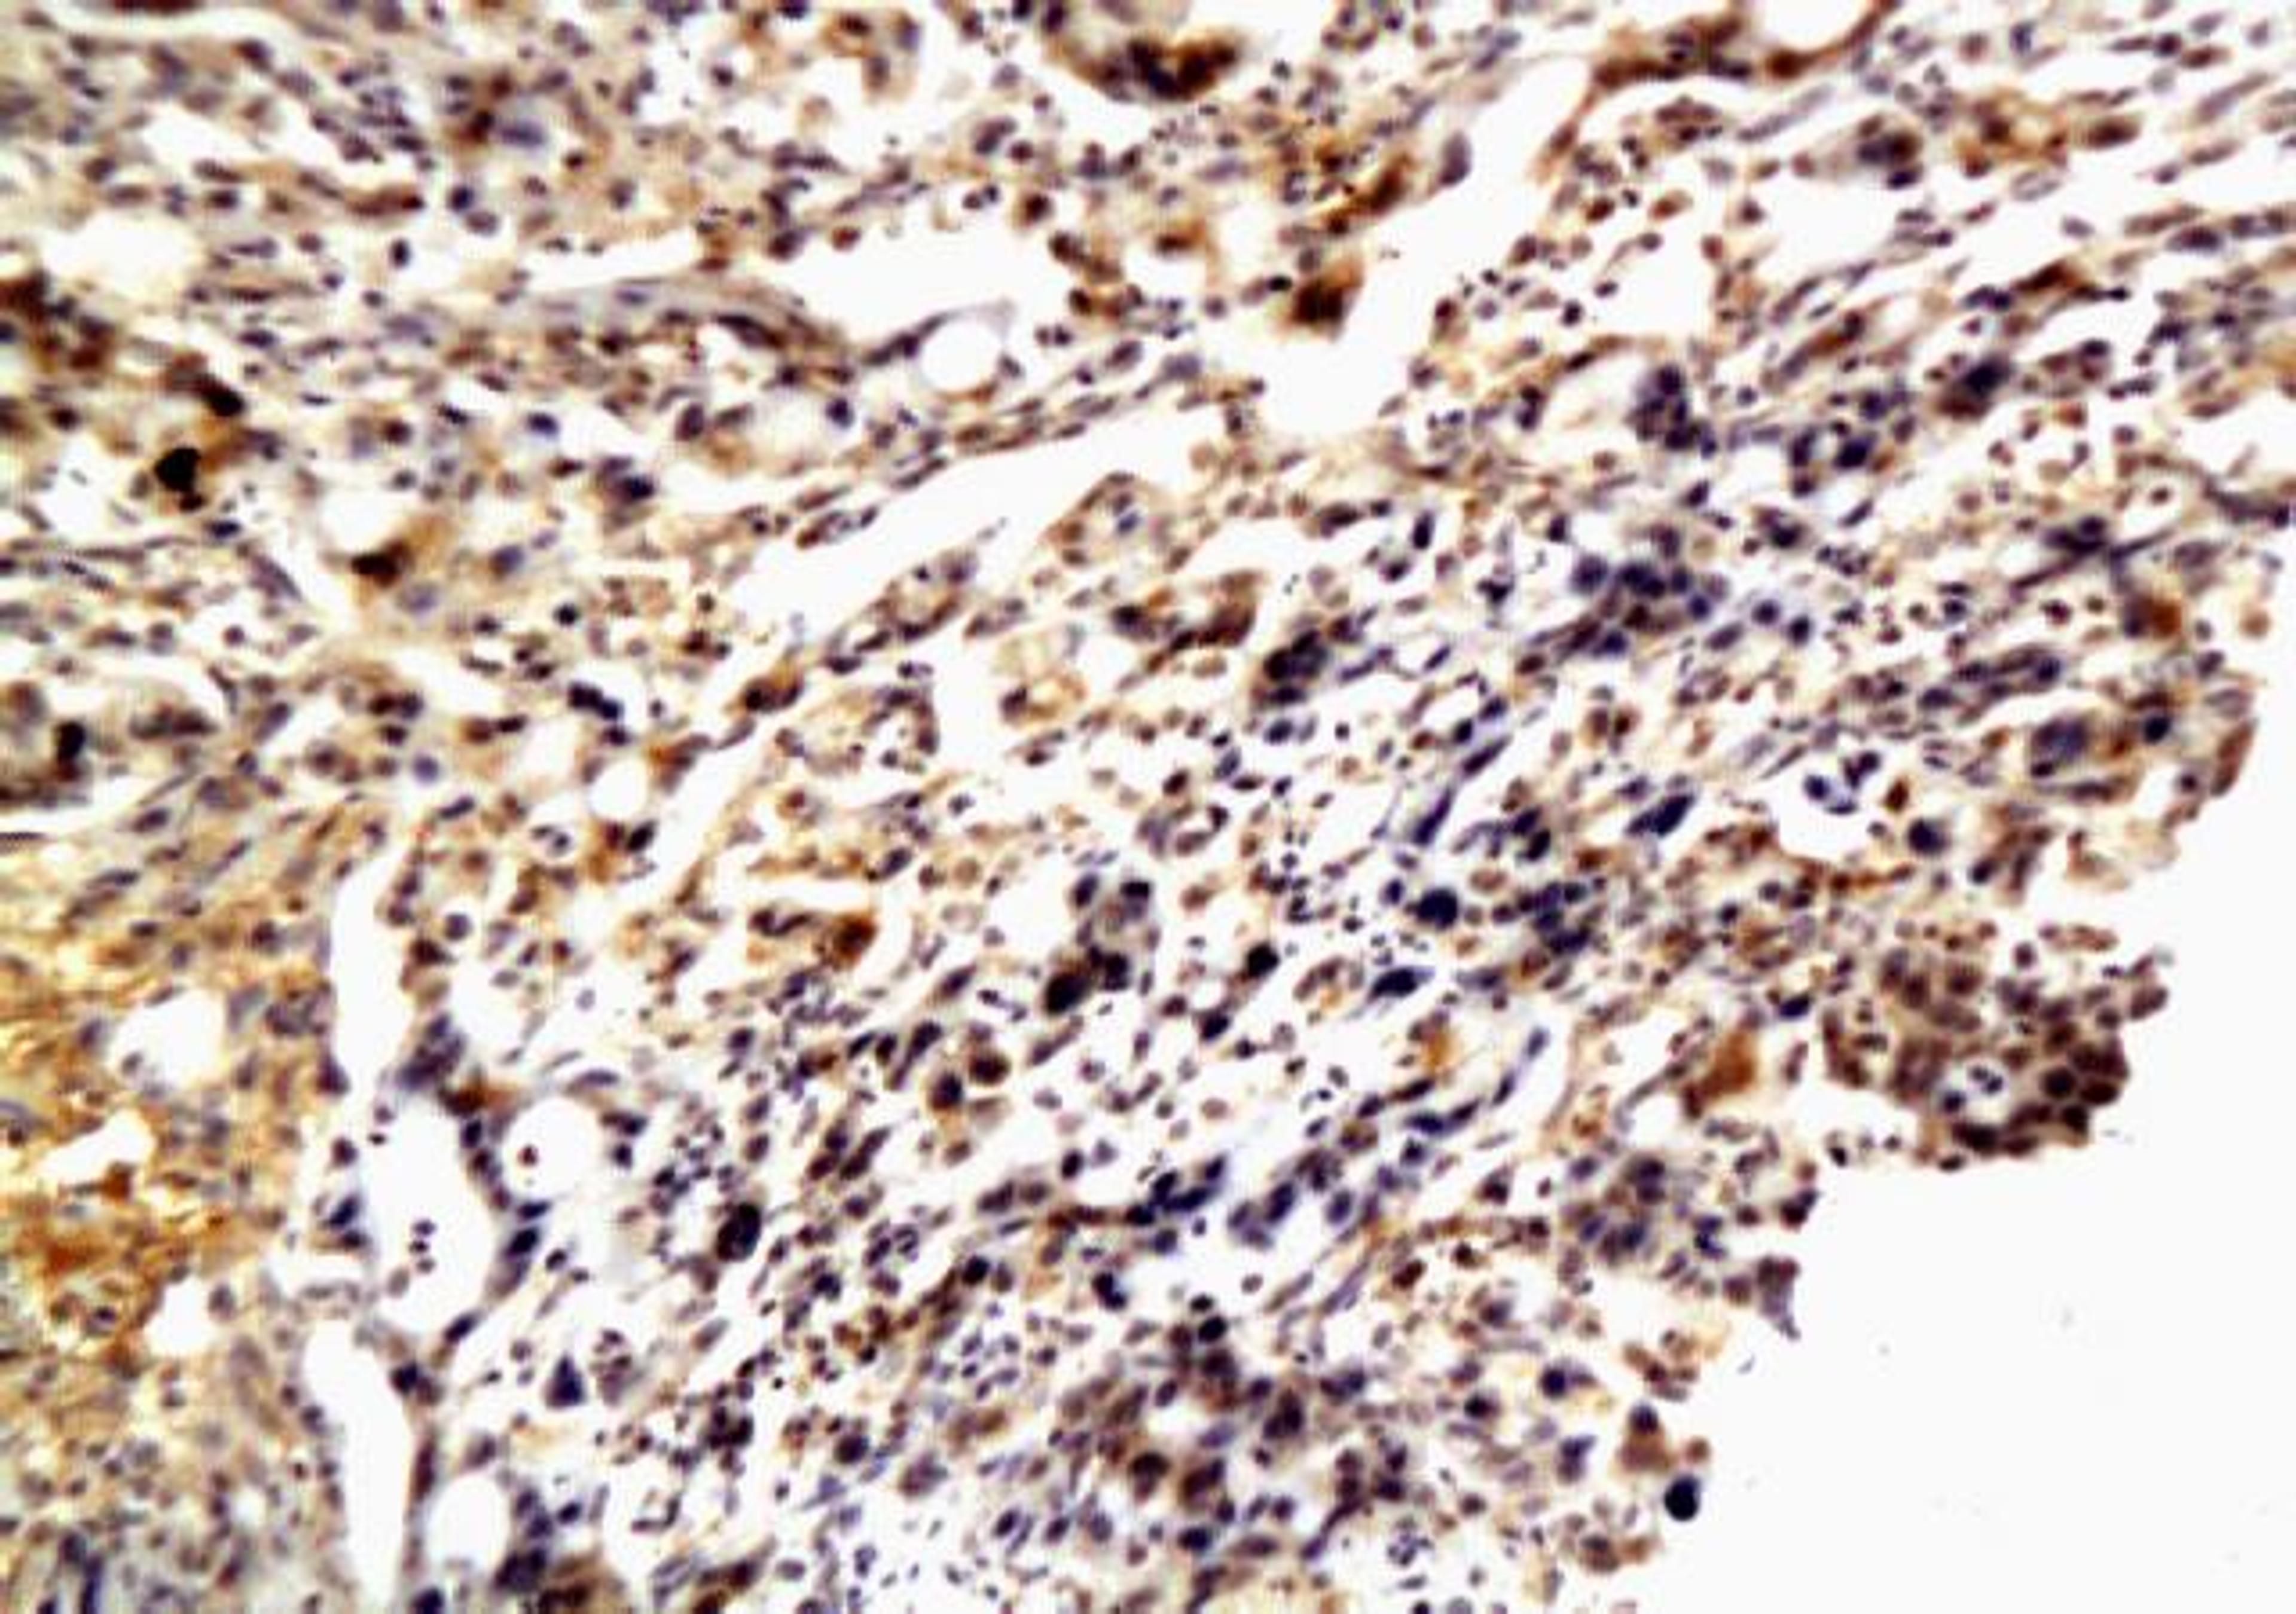
Immunohistochemical staining of paraffin embedded human stomach cancer tissue using MMP2 antibody

SOAT1 antibody
- Manufacturer
- Biorbyt
- Catalog Number
- orb100781
- Host
- Rabbit
- Reactivity
- Bovine, Human, Mammalian, Mouse, Rabbit (Lapine)
- Applications
- ELISA, Immunofluorescence (Paraffin-Embedded Sections), Immunohistochemistry (Frozen Sections), Immunohistochemistry (Paraffin-Embedded Sections)